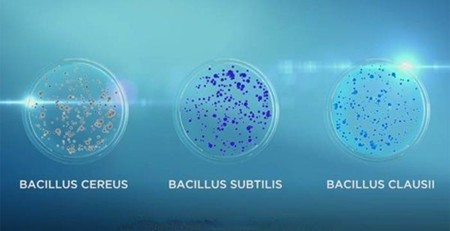

Vi khuẩn Bacillus là một trong những lợi khuẩn được ứng dụng rộng rãi để hỗ trợ và bảo vệ hệ tiêu hóa. Cùng khám phá lợi ích cũng như cách ứng dụng vi khuẩn này.
Vai trò của vi khuẩn Bacillus
MỤC LỤC
-
Đặc điểm của Bacillus
-
Công dụng của Bacillus đối với sức khỏe
-
Ứng dụng của vi khuẩn Bacillus
|
Đặc điểm của vi khuẩn Bacillus
Bacillus là nhóm vi khuẩn hình que, có khả năng sinh bào tử – giúp chúng tồn tại trong điều kiện khô hạn, nhiệt độ cao hoặc môi trường axit. Đây là một trong những nhóm probiotics thế hệ mới, có tính ổn định cao và được sử dụng rộng rãi trong thực phẩm chức năng, xử lý môi trường và y học.
Một số chủng Bacillus phổ biến: Bacillus subtilis, Bacillus clausii, Bacillus coagulans, Bacillus licheniformis...
 Các chủng vi khuẩn Bacillus phổ biến
Các chủng vi khuẩn Bacillus phổ biến
Công dụng của vi khuẩn Bacillus đối với sức khỏe
Bacillus là nhóm lợi khuẩn có khả năng tạo bào tử bền vững, giúp chúng sống sót khi đi qua môi trường axit dạ dày và phát huy tác dụng ở ruột non.
Công dụng của vi khuẩn Bacillus đối với sức khỏe con người bao gồm:
Cân bằng hệ vi sinh đường ruột
Bacillus giúp ức chế sự phát triển của vi khuẩn có hại, đồng thời tạo môi trường thuận lợi cho các lợi khuẩn khác phát triển, từ đó cải thiện tiêu hóa và hấp thu dinh dưỡng.
Giảm rối loạn tiêu hóa
Một số chủng như Bacillus clausii hoặc Bacillus subtilis có tác dụng rõ rệt trong việc giảm tiêu chảy, đầy bụng, táo bón và rối loạn tiêu hóa do dùng kháng sinh.
Tăng cường miễn dịch tự nhiên
Bacillus kích thích cơ thể sản xuất kháng thể và cải thiện hàng rào miễn dịch đường ruột, giúp giảm nguy cơ nhiễm khuẩn và tăng đề kháng với các tác nhân gây bệnh.
Bảo vệ và phục hồi hệ tiêu hóa khi dùng thuốc
Lợi khuẩn Bacillus thường được kết hợp trong men vi sinh để bảo vệ đường ruột khi dùng kháng sinh, hỗ trợ tái tạo hệ vi sinh sau điều trị.
Hỗ trợ giảm viêm và chống dị ứng
Một số nghiên cứu cho thấy Bacillus còn giúp giảm phản ứng viêm nhẹ, hỗ trợ cải thiện viêm da cơ địa, dị ứng thực phẩm hoặc các tình trạng nhạy cảm ở trẻ nhỏ.

Công dụng của vi khuẩn Bacillus
Ứng dụng của vi khuẩn Bacillus
Nhờ vào ưu điểm và lợi ích của mình mà rất nhiều chủng vi khuẩn Bacillus đã được ứng dụng vào trong việc sản xuất các sản phẩm có lợi cho sức khỏe:
Probiotic (men vi sinh)
Nhiều chủng Bacillus, đặc biệt là Bacillus clausii, Bacillus subtilis, và Bacillus coagulans, được sử dụng làm men vi sinh để cân bằng hệ vi sinh đường ruột.
Chúng có khả năng tạo bào tử, giúp tồn tại qua môi trường axit dạ dày và đến ruột non, nơi chúng ức chế vi khuẩn có hại, hỗ trợ tiêu hóa, tăng cường miễn dịch và điều trị các rối loạn tiêu hóa như tiêu chảy, đầy bụng, khó tiêu.
Đặc biệt, men vi sinh Bacillus clausii được sử dụng thường xuyên để bổ sung tăng cường vi khuẩn đường ruột, hỗ trợ điều trị rối loạn tiêu hóa do loạn khuẩn đường ruột ở người sử dụng kháng sinh kéo dài. Sản phẩm an toàn, có sinh khả dụng cao, không gây tác dụng phụ, có thể sử dụng cho cả người lớn, trẻ nhỏ và trẻ sơ sinh.
Sản xuất kháng sinh tự nhiên
Một số loài Bacillus có khả năng sản xuất kháng sinh tự nhiên như:
-
Bacitracin: Từ Bacillus subtilis và Bacillus licheniformis, được sử dụng trong điều trị nhiễm trùng da.
-
Polymyxin: Từ Bacillus polymyxa, hiệu quả trong điều trị nhiễm trùng Gram âm.
Sản xuất enzyme
Bacillus được sử dụng để sản xuất nhiều loại enzyme quan trọng trong y học và công nghiệp dược phẩm.
Kiểm tra vô trùng
Bào tử của Bacillus stearothermophilus (thường được biết đến là Geobacillus stearothermophilus hiện nay) được sử dụng để kiểm tra hiệu quả của các quy trình khử trùng bằng nhiệt (hấp tiệt trùng).
Dược sĩ Thu Hà
Theo Giáo dục & Cuộc sống/Giáo dục & Thời đại
.jpg)